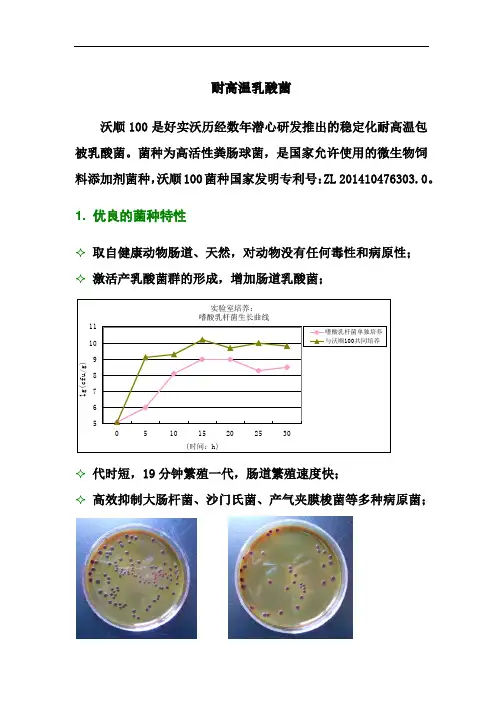

健康仔猪肠道内抗逆性乳酸菌的选育
- 格式:pdf
- 大小:160.76 KB
- 文档页数:2

69202340卷第12猪场兽医VETERINARY仔猪保育阶段最主要的目的是保证保育仔猪健康生长,帮助仔猪应对断奶应激和过渡自己进食,保育期是猪养殖中关键的时期。
保育期对于仔猪来说面对着环境和饮食的巨大改变,需要根据保育仔猪的生理特点进行科学的饲养管理,以此提高猪场的经济效益及保育仔猪的生长性能。
仔猪在出生后21~28 d 即可断奶,断奶后需留原圈饲养1周后转保育舍进行保育,保育时长一般为40~50 d 。
在保育阶段仔猪会被转入一个陌生的环境并与其他仔猪混合,此时仔猪容易发生多种疾病,因此了解保育仔猪的生理特点至关重要。
1 保育仔猪的生理特点1.1 机体发育不完善,抗寒能力差保育仔猪从产房转到保育舍后对温度的变化极为敏感,保育舍温度过低,不但限制仔猪生长发育,还可能引发多种疾病。
同时由于年龄小,各方面机体功能发育不完善,尤其是消化系统。
1.2 生长发育快断奶仔猪从母乳到固体饲料的转化需要仔猪发展消化能,将饲保育仔猪胃肠道疾病的防治方法韦云略(广西柳州市柳江区三都镇农业农村综合服务中心,广西 柳州 545105)作者简介:韦云略(1977—),男,广西柳州人,大专,助理兽医师,主要从事动物疫病防控工作料分解成可以吸收的营养物质,保育仔猪食欲旺盛,饲养水平较高时生长迅速,在保育期间体重可增加1倍。
1.3 抗病能力差,对疾病的易感性高仔猪哺乳时通过乳汁中的抗体进行免疫抵抗,而在保育期间仔猪自身的免疫能力并不能抵抗外界病原,免疫系统相对不够成熟,对疾病抵抗能力弱,猪传染性胃肠炎、猪萎缩性鼻炎等疾病都十分易感。
2 保育仔猪常见胃肠道疾病2.1 猪传染性胃肠炎猪传染性胃肠炎是一种由冠状病毒引起的传染性较强的疾病,具有季节性,冬季疾病发生率较高。
该病传染性强、传播迅速、死亡率较高,仔猪高发。
主要临床表现为精神萎靡、呕吐、脱水、排白色或黄色水样便等症状,严重的仔猪还包含血液凝块。
病理变化特征为小肠及胃中有白色或黄绿色液体,肠壁变薄或出现出血及炎症,保育前期的仔猪胃中含有大量未消化的乳块。


试验研究202310263莱芜仔猪肠道菌群组成初步分析崔景香1,赵纳杰1,孙小桉1,张寒松1,郑乾坤2(1.潍坊科技学院,山东寿光 262700;2.得利斯集团有限公司,山东诸城 262200)摘要:猪的肠道菌群组成与种类及健康状态密切相关,研究健康、品种优良的猪的肠道菌群组成对于养猪业的发展具有积极意义。
本研究采用16S rRNA 高通量测序方法对10日龄莱芜哺乳仔猪腹泻仔猪的粪便进行测序分析。
结果显示,健康仔猪共有优势菌门为厚壁菌门(Firmicutes )、变形菌门(Proteobacteria )和拟杆菌门(Bacteroidetes ),共有优势菌属为乳杆菌属(Lactobacillus );腹泻仔猪共有优势菌门为厚壁菌门(Firmicutes )、拟杆菌门(Bacteroidetes ),共有优势菌属为乳杆菌属(Lactobacillus )。
此外,两组比较,Lactobacillus 、Escherichia-Shigella 、Prevotella _9、Fusobacterium 、Prevotellaceae 属在腹泻仔猪组丰度水平高,而Acinetobacter 、Jeotgalibaca 、Treponema _2、Psychrobacter 属在健康仔猪组丰度水平高。
本研究结果为莱芜猪肠道菌群多样性研究提供基础数据,并为后期调节肠道菌群、促进猪的健康成长提供参考依据。
关键词:莱芜猪;腹泻仔猪肠道菌群;16S 高通量测序中图分类号:S828.5 文献标志码:B 文章编号:1003-8655(2023)10-0001-03莱芜猪是山东省特有的地方猪种,具有高繁殖力、肉质好、耐粗饲和抗病力强等特性。
其中高抗病力特点更是备受关注。
该仔猪肠道微生物菌群相对稳定,断奶应激反应相对较小,对常见致病细菌和病毒所引起的腹泻具有很强的抗病性。
尽管如此,莱芜仔猪轻度腹泻常有发生,这估计和其肠道菌群异常有关,并直接影响到后期猪的生长速度和主要经济性状。

乳酸菌对生猪健康与生产性能的影响
邢俊玲;岳王军
【期刊名称】《畜牧兽医科学:电子版》
【年(卷),期】2022()2
【摘要】生猪饲养管理中,健康养殖模式越来越受到养殖户推崇,传统生猪养殖对生态环境产生不同程度的破坏,同时药物使用不科学使很多病原体对抗生素的耐药性
显著增强,抗生素药物残留所造成的食品安全问题成为消费者普遍关注的热点焦点
问题。
转变传统生猪养殖模式,积极推广无公害养殖技术,是当前生猪养殖领域需要
重点研究的内容。
乳酸菌作为一种优质、安全、高效的益生菌,它能有效调节猪群
的胃肠道环境,有效抑制和杀死各种致病性病原体,改善胃肠道平衡,增强肠道黏膜的免疫功能,维持良好的肠道屏障,让猪群更好地消化利用饲料。
在猪饲料中添加适量
的乳酸菌,能更好地促进生猪健康生长发育。
该文探讨了乳酸菌对新生仔猪、断奶
仔猪、生长育肥猪、母猪的作用,以期为饲养管理方式做出有效调整提供一定参考。
【总页数】2页(P144-145)
【作者】邢俊玲;岳王军
【作者单位】山东省德州市武城县畜牧渔业发展中心
【正文语种】中文
【中图分类】S828.5
【相关文献】
1.乳酸菌和酵母菌复合制剂对肉仔鸡生长性能、屠宰性能和肠道健康的影响
2.乳酸菌对生猪健康和生产性能的影响
3.好实沃乳酸菌对淘汰蛋鸡生产性能和屠宰性能的影响
4.乳酸菌对生猪健康和生产性能的影响
5.乳酸菌素对肉鸡生产性能和屠宰性能的影响
因版权原因,仅展示原文概要,查看原文内容请购买。

益生菌的筛选鉴定及其对断奶仔猪、犊牛生长和消化道微生物的影响一、本文概述本文旨在探讨益生菌的筛选鉴定及其对断奶仔猪和犊牛生长和消化道微生物的影响。
益生菌作为一种对宿主有益的微生物,近年来在动物营养与健康领域受到广泛关注。
本文首先对益生菌的筛选鉴定方法进行概述,包括益生菌的来源、筛选原则、鉴定方法等。
随后,通过综述相关文献和实验结果,分析益生菌对断奶仔猪和犊牛生长性能的影响,并深入探讨其对消化道微生物的调节作用。
本文期望为益生菌在畜牧业中的应用提供理论依据和实践指导,以促进养殖业的可持续发展。
二、益生菌的筛选与鉴定益生菌的筛选与鉴定是本研究的关键环节,直接关系到后续动物实验的效果和准确性。
在筛选过程中,我们遵循了益生菌的安全性、有效性以及适应性的原则,确保所选益生菌既能在动物体内稳定存活,又能发挥其益生作用。
在筛选益生菌时,我们首先考虑了益生菌的来源。
为了获取高质量的益生菌,我们从多种天然环境中收集了潜在的益生菌菌株,包括土壤、植物、动物肠道等。
随后,我们对这些菌株进行了初步的筛选,通过体外试验评估了它们的耐酸性、耐胆盐性以及对病原菌的抑制能力。
只有通过了这些初步筛选的菌株,才会被考虑进入下一步的动物实验。
对于通过初步筛选的益生菌菌株,我们进行了详细的鉴定工作。
我们利用分子生物学技术,如16S rRNA基因测序,确定了菌株的种属信息。
我们对菌株的生理特性进行了深入研究,包括其生长曲线、营养需求、代谢产物等。
我们还对菌株的安全性进行了评估,确保其不会对人体或动物体造成危害。
通过严格的筛选和鉴定流程,我们最终选出了几株具有优良益生特性的益生菌菌株,为后续的动物实验提供了可靠的实验材料。
这些菌株在后续的实验中表现出了良好的生长性能和益生效果,为断奶仔猪和犊牛的生长和消化道微生物的调节发挥了重要作用。
三、益生菌对断奶仔猪生长和消化道微生物的影响断奶是仔猪生长发育过程中的一个重要阶段,然而,断奶应激往往会导致仔猪出现腹泻、生长受阻等问题。

耐高温乳酸菌沃顺100是好实沃历经数年潜心研发推出的稳定化耐高温包被乳酸菌。
菌种为高活性粪肠球菌,是国家允许使用的微生物饲料添加剂菌种,沃顺100菌种国家发明专利号:ZL 201410476303.0。
1. 优良的菌种特性✧取自健康动物肠道、天然,对动物没有任何毒性和病原性;✧激活产乳酸菌群的形成,增加肠道乳酸菌;✧代时短,19分钟繁殖一代,肠道繁殖速度快;✧高效抑制大肠杆菌、沙门氏菌、产气夹膜梭菌等多种病原菌;对照组乳猪粪便中大肠杆菌菌落猪用沃顺100组乳猪粪便中大肠杆菌菌落✧产生L-型乳酸和短链脂肪酸,合成B族维生素等;✧更适应肠道环境,形成菌膜屏障,保护肠道粘膜;✧刺激免疫系统,提高免疫力●菌种选育流程2. 国际领先、成熟的微囊化生产工艺采用国际领先的微囊化前包被工艺、流化包被后处理工艺的完美结合,实现乳酸菌微囊化四层包被处理,产品稳定性强,抗逆性好。
乳酸菌微囊化工艺国家发明专利号:ZL 201210393526.1。
产品完全按照ISO9001和HACCP 质量和管理体系进行生产。
沃顺100剖面示意图 沃顺100成品图●核心包被材料(食品级)特点介绍:●生产工艺流程四项核心工艺:3. 沃顺100产品特色耐高温、稳定性强乳酸菌经过多层微囊化包被处理后能够耐受高温制粒、胃酸、胆盐等不良环境,精选的包材与饲料中抗生素、维生素和其他活性添加剂不发生拮抗作用。
好实沃稳定化耐高温乳酸菌经过85℃高温3分钟处理后存活率达95%以上,经过95℃高温3分钟处理后存活率仍达85%以上。
以下是广东省微生物分析检测中心的检验报告:超高速管式离心机成品库房流化包被机肠道定点释放高肠溶性包膜材质使乳酸菌微囊到达肠道才能被快速地溶解,在胃内不溶解。
胰腺分泌脂肪酶乳酸菌微囊遇到脂肪酶,迅速崩解释放。
微囊分解示意图菌种活性高、安全性高菌种源自健康动物肠道,采用国际领先的16sRNA分子鉴定技术进行菌种鉴定,经过肠道粘附力、抑菌、增殖速度的层层筛选,并进行严谨的动物试验,菌种活性高、安全性高、抑菌能力强,到达肠道能够迅速增殖并发挥益生作用。

华中农业大学硕士学位论文猪源益生乳酸菌的筛选及发酵工艺研究姓名:***申请学位级别:硕士专业:发酵工程指导教师:***200706013结果与分析3.1乳酸茵的筛选分离试验分离了38株乳酸菌,它们在MRS琼脂平板上为圆整、光滑、隆起、灰白色露滴样小菌落,革兰氏染色阳性无芽孢的球菌或杆菌。
图3.1孔内为乳酸菌发酵液,平板表面为指示菌液。
抑菌圈大的表明该菌株抑菌特性强,没有抑菌圈的表明对指示菌没有抑制特性。
进一步的抑菌试验筛选到3株对各株指示菌均有较强抑菌特性的乳酸菌,它们分别为LAB01,LABl2和LAB31。
图3.1筛选分离的乳酸菌抑制指示菌Antimicrobialactivitiesofisolateds删nsagainstindicatedbacteriaFig.3.13.2乳酸茵的鉴定3.2.1形态特征油镜观察(图3.2)表明,3株乳酸菌菌体形态为杆状,单个、成对或链状排列。
图3.2L气BOl、I.ABl2和LAB31的形态特征Ftg.3.2MorphologicalpropertyofLAB01,LABl2andLAB3l3.2.2主要生理生化鉴定和16SrDNA保守序列分析将表3.1鉴定结果与《伯杰氏细菌鉴定手册》上关于乳酸菌属的描述相对照,LAB01属于乳酸杆菌属,LABl2和U母31属于肠球菌属。
3株乳酸菌16SrDNAPCR扩增产物比对结果:菌株LAB01与Lcase/的16SrDNA序列同源性达到了100%,I_ABl2--与E.faecium的16SrDl妣序列同源性达到了99.8%,LAB31与Efaecalis的16SrDNA序列的同源性达到了99%。
综上两种方法,初步鉴定:LA.B01为干酪乳杆菌伍.c船们、LABl2为屎肠球菌幔。

解决仔猪断奶问题的几种添加剂1 酸化剂和酶制剂酸化剂在调节胃肠道酸度,激活胃蛋白酶,调节肠道微生态平衡,降低仔猪营养性和细菌性腹泻方面,发挥着重要作用。
酸化剂分为无机酸化剂和有机酸化剂两种,无机酸化剂主要有盐酸、硫酸和磷酸;有机酸化剂主要有柠檬酸、延胡索酸、乳酸、甲酸、丙酸等。
一般断奶仔猪饲粮系酸力为:含石粉的饲粮为30~40;含石粉+0.1~0.3%市售酸化剂的饲粮为30~35;含有机复合钙的饲粮为23~25;含有机复合钙+1.5~2.0%柠檬酸的饲粮为17~20;而断奶仔猪饲粮的最佳系酸力范围为15~20。
无机酸的特点是,酸性强、刺激口腔粘膜(适口性差)、腐蚀设备,且解离快、对胃壁刺激大;而有机酸(乳酸)虽适口性好,但酸性弱,添加量又很大,使用当中各有各的不足。
酶制剂可以提高畜禽生产性能和减少排泄物的污染,同时也为开辟新的饲料资源、降低饲料生产成本提供了有效的途径。
饲料用酶制剂主要可分为两类消化性酶和非消化性酶。
消化性酶:主要辅助动物消化道酶系作用,降解淀粉和蛋白质成为易被吸收的小分子物质(α-淀粉酶、糖化酶、酸性蛋白酶和中性蛋白酶)。
非消化性酶:通过破坏植物细胞壁,把不可利用的多糖分解成可被消化吸收的小分子物质,或催化某种反应使其营养物质释放出来,可供机体吸收利用(木聚糖酶、果胶酶、甘露聚糖酶、β-葡聚糖酶、纤维素酶等非淀粉多糖酶和植酸酶)。
根据所含酶的种类,又分为饲用单一酶制剂和复合酶制剂。
一般来说,复合酶制剂比单一酶制剂效果好,但并不意味着复合酶制剂中酶种类愈多愈好。
复合酶制剂有两种,多数由几种单一酶混合调制而成,还有一种是由一种微生物产生含多种酶系的复合酶制剂,后者具有很好的发展前途,与单一酶制剂相比,复合酶制剂中存在多种酶活,其中主要为非淀粉多糖酶,某些产品还含有一些外源消化性酶,如蛋白酶、淀粉酶等;复合酶中各种酶发挥相辅相成的效果,在各种酶共同作用下,动物饲料中一些抗营养因子被破坏,因而可以达到较好效果。

影响仔猪肠道健康的因素:1.日粮抗营养因子日粮抗营养因子包括豆粕中的胰蛋白酶抑制因子、凝集素、抗原蛋白、棉粕中的棉酚、植酸等等,其中豆粕中的抗原蛋白是造成仔猪肠道功能损伤的主要原因。
球蛋白和β-伴球蛋白是豆粕中两种最重要的抗原蛋白,前者刺激肥大细胞释放组胺,引起上皮细胞通透性增加和黏膜水肿;后者引起肠道形态变化,表现为肠道绒毛萎缩、脱落。
2.病原微生物新生幼畜的胃肠道是无菌的,随后母源性和外部环境的微生物定植于肠道中,构成一个相对稳定的微生态系统。
猪肠道内大约有14个属的400~600种微生物,数量达到1014个,是体细胞的10 倍。
仔猪断奶后,乳酸杆菌、福特氏乳酸菌和嗜酸乳酸杆菌的数量显著降低,其原因为需要复杂营养供应的乳酸菌受到了断奶后仔猪采食量下降的影响;另一方面,日粮组分的变化,如日粮中含有的抗营养因子,造成了肠道受损伤和炎症,增加了被外部病原微生物感染的机会。
3.饲料加工调制断奶仔猪由采食母乳到采食饲料,经历一个巨大的转变,饲料加工处理方式不同,对仔猪肠道健康影响也不同,如原料熟化与否,颗粒料与粉料及固态料与液态料等。
从消化率的角度出发,谷物和植物性饲料(玉米、豆粕、大豆、小麦)至少需要50%以上的熟化处理,以保证对淀粉的糊化和对抗原的灭活效果。
经过熟化和制粒后,可以减少日粮抗营养因子、病原微生物等的数量,从而减少对肠道黏膜的过敏反应与损伤。
有报道不同料形对断奶仔猪消化生理的影响,与粉料相比,颗粒料可显著提高仔猪日采食量,提高内源酶的活性;与固态料相比,液体料可显著降低仔猪的腹泻,提高小肠绒毛的高度。
4.霉菌毒素霉菌毒素是产毒霉菌在粮食或饲料上生长繁殖过程中产生的有毒二次代谢产物,对动物肠道健康影响很大。
试验标明,镰刀霉菌毒素中的脱氧雪腐镰刀菌烯醇(DON)和玉米赤霉烯酮(ZEN)可造成新生仔猪肠上皮细胞氧化损伤,并抑制其增殖,导致细胞膜完整性受损,抑制消化酶的活性及对营养物质的吸收。

猪不同发育阶段肠道微生物菌群特征分析陈宝剑,吴永绍,覃兆鲜,张冰,潘天彪,关志惠,陈少梅,吴柱月,谢炳坤*(广西壮族自治区畜牧研究所,广西家畜遗传改良重点实验室,广西南宁 530005)摘 要:为研究不同生长发育阶段猪肠道微生物菌群结构与特征的差异,本研究将50头28日龄体重8 kg左右的杜×长×大断奶仔猪随机分为5栏,分别在第60、90、120、150、180日龄饲喂前,从每栏随机挑选5头猪,每头采取100 g左右的新鲜粪样,采用16S rRNA高通量测序技术对微生物多样性进行研究。
结果显示:通过菌群分类学分析发现,不同时期猪肠道微生物分布于22个门、42个纲、74个目、119个科、321个属和579个种,厚壁菌门(Firmicutes)、拟杆菌门(Bacteroides)、螺旋体门(Spirochaetae)为主要优势菌门,不同时期的特异菌群显著差异;对丰度值前30的肠道菌群与血液免疫抗体浓度进行相关性关联分析发现,IL-2浓度与12个菌群存在显著相关性,IL-6浓度与14个菌群存在显著相关性,IgG浓度与12个菌群存在显著相关性,IgM浓度与11个菌群存在显著相关性,IgA浓度与26个菌群存在显著相关性。
综上表明,猪肠道微生物菌群结构与组成在不同生长发育阶段均存在显著差异,对猪免疫性能具有重要作用。
关键词:猪;肠道微生物多样性;16S rRNA测序中图分类号:S828.2 文献标识码:A DOI编号:10.19556/j.0258-7033.20200313-01猪肠道中微生物主要是厌氧菌和兼性厌氧菌,其中厚壁菌门和拟杆菌门占90%以上,在维护机体健康、提高机体免疫力、营养物质吸收代谢等方面发挥着重要作用[1]。
不同时期猪肠道微生物菌群有显著差异,胚胎时期肠道处于一种无菌状态,分娩过程中受母体产道、粪便以及周围环境的影响开始出现微生物,主要以大肠杆菌、葡萄球菌等为主[2]。
猪源乳酸菌的分离及其生物学性能研究李琳琳;王雅婷;杨欣;周罗雄;王利红;杜恩岐【摘要】[目的]从猪新鲜粪便和肠道黏膜中筛选乳酸菌,为猪益生剂饲料添加剂提供理论依据和可靠菌种.[方法]采集陕西八眉猪的粪便和肠道组织,分离纯化乳酸菌,通过体外耐酸、耐胆汁试验以及抑菌试验和黏附试验,筛选特性优良的益生菌,用16S rRNA基因序列系统发育树确定其分类地位.采用小鼠安全性检验试验,检测筛选菌株的安全性.[结果]筛选出一株耐受性和抑菌性良好,生长曲线稳定且黏附性较好的乳酸菌,命名为FB027;另一株抑菌性和黏附性良好,生长曲线稳定且耐酸、耐胆盐较好的乳酸菌,命名为SE013.16S rRNA基因序列系统发育树分析发现,FB027为非解乳糖链球菌(Streptococcus alactol yticus),进化与同属的血红链球菌Streptococcus sanguinis(GenBank登录号CP000387.1)同源性最高,SE013为肠系膜明串珠菌(Leuconostoc mesenteroides),进化与同属的伪明串珠菌Leuconostoc pseudomesenteroides(GenBank登录号AB572039.1)同源性最高.小鼠安全性检验试验发现,连续2周口服乳酸菌FB027和SE013,小鼠健康状况良好,行为、生长、采食量和病理组织剖检均无明显异常.[结论]分离获得了性能优良的2株乳酸菌,其在猪饲料添加剂方面有潜在的应用前景.【期刊名称】《西北农林科技大学学报(自然科学版)》【年(卷),期】2016(044)002【总页数】7页(P1-7)【关键词】猪;乳酸菌;分离鉴定;生物学特性【作者】李琳琳;王雅婷;杨欣;周罗雄;王利红;杜恩岐【作者单位】西北农林科技大学动物医学院,陕西杨凌712100;西北农林科技大学动物医学院,陕西杨凌712100;西北农林科技大学动物科技学院,陕西杨凌712100;西北农林科技大学动物科技学院,陕西杨凌712100;西北农林科技大学动物科技学院,陕西杨凌712100;西北农林科技大学动物医学院,陕西杨凌712100【正文语种】中文【中图分类】S852.6乳酸菌(Lactic acid bacteria,LAB)是指一类可发酵碳水化合物,产生大量乳酸的革兰氏阳性球菌或杆菌的统称,包括乳杆菌属、明串珠菌属、片球菌属、链球菌属和双歧杆菌属等。
健康仔猪肠道内抗逆性乳酸菌的选育邱进杰1,熊 焰1,杨 智2(1.四川农业大学动物医学院,四川雅安625014;2.四川七环公司良种猪场,四川温江611100)
中图分类号:S852.6 文献标识码:B 文章编号:052926005(2008)0420086201
仔猪腹泻在兽医临床上十分普遍,它严重的影响和制约着仔猪的存活率及养殖者的经济收入。市场上治疗仔猪腹泻的药物很多,但存在药物残留问题。研究开发无毒、无副作用和无残留的益生菌制剂已成为热点课题。1998年美国动物饲粮管理协会(AAFCO)年鉴公布了43种可用作益生素的菌种,其中半数以上是乳酸菌(lacticacidbacite2ria)[1]。因此,乳酸菌在益生菌制剂的研究和生产
中扮演着重要的角色。本试验的目的是从健康仔猪的新鲜粪便中分离、选育出抗逆性(耐酸、耐胆盐)强的乳酸菌菌株,用于防治仔猪肠道疾病。1 材料与方法1.1 样品 健康乳猪新鲜粪便,采自四川多个规模化养猪场。1.2 培养基 增菌培养基、分离培养基和生化培养基,参见文献[2]配制。1.3 细菌的分离鉴定 按常规方法进行细菌的分离鉴定[324]。1.4 耐胆盐试验 取24h乳酸菌新鲜培养物,用灭菌生理盐水作10-4~10-7稀释(选取一适宜的稀释度),用微量加样器吸取0.1mL乳酸菌稀释液均匀涂布于胆盐浓度分别为0%,0.2%,0.3%,
0.4%,0.5%MRS营养琼脂平皿上,于37℃温箱中培养24~48h,进行菌落计数。每个菌株作3个平行。计算存活率。
1.5 耐酸试验 将24h乳酸菌培养物按1%(V/V%)接种于pH2.5的MRS肉汤中,接种后于37℃培养箱中培养。分别在0h和8h,取出适量的培养物用灭菌生理盐水进行梯度稀释至10-3~10
-5(选取一
适宜的稀释度),用微量加样器吸取0.1mL菌液于MRS营养琼脂平皿上均匀涂布,置入37℃培养箱中培养24~48h,进行菌落计数。每个菌样做3个平行。计算存活率s=h8/h0。2 结果2.1 细菌的分离鉴定 本试验分离到5株乳酸菌,编号为6#、7#、9#、19#、22
#
,根据革兰氏染色镜检
和相关生化试验指标,参见《伯杰细菌鉴定手册》[3],
最终鉴定为:菌株6#为乳酸乳杆菌,7#为乳链球菌,
菌株9#为懒惰乳杆菌,菌株19#为嗜酸乳杆菌,菌株22#为嗜酸乳杆菌。2.2 耐胆盐试验 菌株6#、7#、19#、22#能耐高达
0.3%以上的胆盐,乳酸菌在不同胆盐浓度下的存活率见图1。
表1 菌株6#、7#、19#、22#在pH2.5的MRS肉汤中培养8h活菌数及存活率菌号时间平皿1活菌数平皿2活菌数平皿3活菌数平均活菌数(h)8h存活率(s=hs/h
0)
6#0h2.7×1083.0×1082.2×1082.6×108167.63%8h4.0×1084.5×1084.4×1084.3×10
8
7#0h8.2×1078.1×1078.1×1078.1×1070.49%8h5.0×1063.0×1064.0×1064.0×10
6
19#0h2.6×1072.1×1072.4×1072.0×107106.84%8h2.5×1072.4×1072.6×1072.5×10
7
22#0h3.2×1073.5×1073.1×1073.1×10790.03%8h2.7×1072.7×1072.9×1072.8×10
7
注:菌株6#稀释至10-7,菌株7#、19#、22#稀释至10-5。
收稿日期:2006208210
通讯作者:熊焰,E2mail:xyan2004@hotmail.com
2.3 耐酸试验 耐酸结果见表1:菌株6#、7#、
19#、22#在pH2.5的MRS肉汤中培养8h,其存活
率分别为167.63%、0.49%、106.84%、90.03%。
68中国兽医杂志2008年(第44卷)第4期 ChineseJournalofVeterinaryMedicine 超抗原———在养殖业中应被重视的致病因子刘晓宁1,何世成2,孔先坤3,胡东健4,谭 双4,余旭平4(1.杭州余杭区农业局物流中心,浙江杭州311112;2.湖南省兽医总站,湖南长沙410007;
3.杭州余杭区畜牧兽医局,浙江杭州311100;4.浙江大学动物科学院,浙江杭州310029)
中图分类号:S852.4 文献标识码:E 文章编号:052926005(2008)0420087203
超抗原是指浓度低于一般抗原(conventionalantigens)即能刺激带有特殊TcR2Vβ(或TcR2Vγ)的T细胞大量增生,并从而改变机体免疫系统自身稳定性的一类蛋白质抗原分子。它主要是一些细菌的外毒素或逆转录病毒的基因产物。超抗原的概念在1989年由White提出以后,其强大的T细胞激活作用,在人医学界和免疫学界引起了巨大的反响,并迅速成为了20世纪90年代世界性研究的前沿课题之一。介绍如下。1 种类 超抗原可分为内源性超抗原和外源性超抗原两大类。内源性超抗原主要是指某些逆转录病毒的基因产物,现在研究的比较详细的是逆转录小鼠乳腺瘤病毒(MMTV)编码的一种称为次要淋巴刺激(MLS)抗原,亦称病毒性抗原。外源性超抗原主要是指某些细菌产生的外毒素,因此也称为细菌性超抗原。目前研究所发现的细菌性超抗原主要有:①葡萄球菌类:葡萄球菌肠毒素(SEA、SEB、SEC123、SED、SEE)、表皮剥脱毒素(EXFA、B)、毒性休克综合征毒素21(TSST21);②链球菌类:收稿日期:2007203223作者简介:刘晓宁(19822),女,硕士,从事动物检疫工作通讯作者:余旭平,电话:0571286971096;E2mail:yuxp@zju.edu.cn链球菌M蛋白(MP)、致热外毒素(SPE)A、B、C。另外,根据所激活的细胞种类,超抗原又可分为T细胞超抗原(T2SAg)和B细胞超抗原(B2SAg)。
T2SAg可激活大量的T细胞,而B2SAg则主要刺激B细胞的大量增殖。2 作用机理以及与普通抗原和有丝分裂源的差异 我们知道,异种抗原活化T细胞的机制是免疫应答的中心环节,T细胞受体(TCR)2抗原肽2MHC三分子复合体是机体特异性免疫应答的分子基础,机体的免疫特异性主要取决于TCR对抗原肽和MHC复合结构的识别,即抗原肽2MHC复合分子对带有特异TCR受体结构的T细胞作克隆性选择。成熟T细胞的TCR由α和β两条链组成,每条链均有两个功能区,即N端的可变(V)区,C端的恒定(C)区。V区是特异性抗原的结合部位,具有高度可变性。V区含众多的基因片段,α链的V区基因包括多个Vα、Jα等片段,β链的V区基因包括多个Vβ、Dβ、Jβ等片段。在细胞发育过程中,这些基因片段经过重排,形成上千万个特异性不同的TCR基因,编码为数极多的TCR,以适应不同细胞识别各种不同的特异性抗原。普通外源性抗原在激活CD4
+
T细胞的过程
中,首先是结合到APC的表面,然后通过吞噬、胞吞
3 讨论乳酸菌制剂以口服的方式饲喂动物,必须具备耐受胃内低pH和肠道内较高胆盐的能力。初生仔猪虽有胆汁分泌,但是分泌量很少,出生后3周内胆汁增加缓慢,一般在0.03%~0.3%范围内波动[5],菌株6#、7#、19#、22#能耐高达0.3%以上的胆盐,与文献[627]报告的菌株相比,菌株6#、7#、19#、22#是胆盐耐受能力较强的乳酸菌菌株。作者研究结果显示[7],仔猪胃内pH维持在3左右,小肠在4~5,大肠在5以上。菌株6#、19#、22#在pH2.5的环境中作用8h能达到90%以上的存活率,完全能适应仔猪胃肠道酸性环境。作为益生菌的乳酸菌必须是那些被公认为安全的微生物(GRAS微生物),并且要有抗胃肠道不利环境的能力。以上试验结果表明,菌株6#、19#、22#是耐酸、耐胆盐能力较强的菌株,符合农业部1999年公布的可用于生产上的安全菌种。利用乳酸菌制剂调节仔猪肠道菌群,抑制病原细菌的生长,对降低药残,改善猪肉品质,无疑是一理想的途径,也是今后国内外在防治猪胃肠道疾病及提高猪自身免疫力的发展方向。参考文献:
[1] EwingWN.TheLivingGut[M].England:UniversityofNotinghan,1994:49.[2] 郭本恒.益生菌[M].北京:化学工业出版社,2004:37239.[3] 布坎南RE.伯杰氏细菌鉴定手册[M].8版.北京:科学出版社,1984:6772830.
[4] 方祥,胡文峰.乳酸菌的分离鉴定及其生长特性[J].中国微生态杂志,2000,12(5):2622264.
[5] GilllandS,StalevTE,BushLJ.ImportanceofBileToler2anceofLactobacilusacidophilusUsedasaDietaryAdjunct[J].JournalofDairyScience,1984(12):304523050.[6] 王傅彬,王永绅,朱国强,等.动物源乳杆菌筛选及生物特性参数测定[J].江苏农学院学报,1987,18(1):125.
[7] 程立中,沙涛.人体嗜酸乳杆菌的分离与筛选[J].云南农业大学:自然科学版,1998,20(2):1082111.
78 ChineseJournalofVeterinaryMedicine 中国兽医杂志2008年(第44卷)第4期